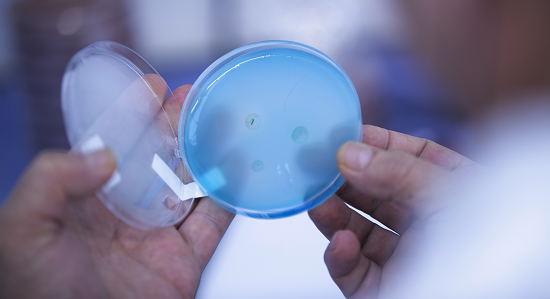

- Home
- Lab-services
- Lab-disciplines
Lab-disciplines

The Royal GD laboratory is one of the largest and most modern laboratories in the world. We offer the following laboratory disciplines:
- Bacteriology
- Clinical-chemistry
- Immunology and serology
- Molecular-biology and DNA-tests
- Parasitology
- Pathology: cytology/histology
- Veterinary pathology
- Virology
- Water testing
Bacteriology
Our laboratory employs diverse methods to track pathogenic bacteria in veterinary settings, covering veterinary bacteriology, water microbiology, and food bacteriology. We conduct a broad spectrum of tests, including those developed in-house by GD, totaling 350,000 bacteriological tests annually using classical culture methods. Testing occurs across multiple departments, utilizing classical culture, microscopic examination, molecular biology (PCR), and immunological methods, many of which are developed internally.
Test methods
In addition to classical culture and microscopy, we employ serological (e.g., ELISA), histological, and molecular-biological (PCR) tests to detect pathogens and toxins. We prioritize faster, more efficient, and cost-effective methods meeting quality standards. Our ELISA facility processes 15,000 tests daily, examining organs, tissues, milk, blood, and feces. Much of our testing supports health and monitoring programs, covering various diseases in poultry, cattle, swine, and horses. After identification, we conduct susceptibility testing to guide antibiotic therapy and minimize resistance development. Our methods:
- Autogenous vaccines: In the absence of registered vaccines, GD produces tailored autogenous vaccines, a collaborative effort between pathology and bacteriology departments. Once the pathologist confirms the cultured agent as the disease cause, we produce farm-specific vaccines. Our Diagnostics
- Bacteriological cultures: We initially culture pathogenic microorganisms from representative samples. Incubation durations vary, with identification based on morphological and physiological properties, biochemical, MALDI-TOF MS, or serological testing.
- Susceptibility testing: Antibiotic susceptibility testing informs farm-level therapy, conducted via microbroth dilution assays.
- Microscopic testing: Various staining techniques, including Gram staining and immunofluorescence, provide rapid bacterial assessments.
- PCR testing: We increasingly utilize PCR for rapid identification and quantification of specific DNA or RNA fragments, particularly for Salmonella spp., Mycobacterium paratuberculosis, mycoplasmas, and Pasteurella multocida toxin genes.
- Serological methods: ELISA, the primary method, swiftly detects antibodies in milk or serum. Our automated ELISA facility conducts millions of tests annually, supplemented by other serological tests like agglutination and serum neutralization.
Clinical-chemistry
GD's clinical-chemical and haematological laboratory tests various types of samples mainly for chemical characteristics. The clinical-chemical laboratory mainly uses standardised, internationally recognised methods. GD has reference values of various parameters for every animal species.
The private practitioner decides about a combination of tests after consulting our specialists. The results of this combination will provide the veterinarian information about the situation in a herd of individual animals, and the diagnosis can then be made. The clinical signs on a farm form the basis for this decision. Based on the diagnosis, the veterinarian and farmer can take the proper measures. The methods used by GD for clinical-chemical testing include the following:
- Capillary electrophoresis for serum proteins. With this technique proteins in the serum are separated using a thin capillary and high voltage. Then the proteins are demonstrated by light absorption.
- Immulite-analyser for analysing hormones and vitamins in blood.
- Automatic cell counters. These appliances are used for counting and demonstrating the various red and white blood cells.
- Clinical-chemical analysers are used for determining other blood components such as urea, glucose and enzymes.
- ICP (induced coupled plasma) is a technique that is used to determine minerals and trace elements.

Immunology and serology
ELISA
The most popular serological test method is ELISA (Enzyme-linked Immunosorbent Assay), which is used to demonstrate antibodies against micro-organisms (e.g. bacteria, viruses and parasites). ELISAs are based on the principle that the antibodies in question, or parts thereof, attach to a carrier (indirect ELISAs) or compete with a specific labelled antibody (blocking ELISAs), with attached antibodies then being made visible by staining. GD Animal Health carries out millions of ELISA tests every year. To do this, GD Animal Health uses ELISA robots, though ELISAs are also carried out by hand, with a capacity of 15,000 tests per day. In addition to ELISA, the GD Animal Health laboratory carries out other serological tests, such as various agglutination tests (HI tests), agar-gel immunodiffusion tests and serum neutralisation tests. Several commercially available ELISAs are used, but when kits are not available, GD Animal Health develops in-house ELISAs for routine testing.
Haemagglutination Inhibition tests
Haemagglutination Inhibition tests (HI tests) are used for viruses that can cause haemagglutination: the virus forms complexes with erythrocytes, resulting in a characteristic clotting. If specific antibodies against these viruses are present in the test sample, they attach to the virus and haemagglutination is prevented or inhibited.
Complement Fixation test
In case of the Complement Fixation test, haemolysis of erythrocytes is inhibited when specific antibodies in the test sample form complexes with antigen and complement in the test system. In the absence of specific antibodies, the complement remains in free solution, then binds to the erythrocytes after which lysis of the erythrocytes occurs. CFT is used for detecting antibodies against Brucella and M. paratuberculosis, for example.
For Serum Neutralisation (SN) we use a several test systems with various cells. Specific virus antibodies in the blood test sample are first given time to react with the virus in the test system, after which cells are added with the result that the virus is neutralised or is no longer capable of infecting cells. In the absence of specific antibodies, infection occurs. The effect of such an infection is visible under the light microscope because infected cells are destroyed (cytopathogenic effect), or infection is made visible by IPMA.
Molecular-biology and DNA-tests
PCR testing (polymerase chain reaction)
This test method is used increasingly within the GD Animal Health laboratory. The principle is based on amplification of a specific fragment of DNA or RNA originating from a bacteria, a virus or a parasite. This DNA or RNA fragment is characteristic of the pathogen to be identified and can be used to detect the pathogen and to distinguish it from other bacteria, viruses, parasites and host DNA and RNA present.
Almost all PCR tests routinely used in the GD Animal Health laboratory are based on the real-time PCR technique. This makes it possible to observe the reaction during progress (real-time), shortens the time to results, and decreases the contamination risk compared to conventional PCR. What is known as ‘real-time PCR’ makes it possible to identify a specific pathogen as well as to measure the number of DNA-copies or pathogen/ml present in the material within one day. GD Animal Health routinely uses various PCR tests – in many cases developed in our own R&D lab or in cooperation with other research institutes. GD Animal Health has developed more than 50 different PCR tests (e.g. PRRSV, BVDV, Neospora, Salmonella spp, paratuberculosis, mycoplasmas and toxin genes of Pasteurella multocida).
In addition to diagnostic tests, GD Animal Health also offers other advanced molecular-biological techniques, such as sequence analyses, fingerprinting and genotyping.
DNA testing
Dr. van Haeringen Laboratorium (VHL) is an official partner of GD Animal Health. VHL specialises in conducting DNA tests in animals, plants and micro-organisms.
Together with Holbigenetics, VHL has developed special CombiGen® packages to detect genetic disorders in dogs. Each CombiGen® package is created for a specific system condition and contains multiple DNA tests. The following packages are available: CombiGen Puppie®, CombiGen® Mobility, CombiGen Surgery®. In addition to the CombiGen® packages, VHL also offers CombiBreed® packages. These include optimal combinations of DNA testing for a specific breed.
VHL also has two packages to test DNA in cats:
Submitting samples
Please submit samples for DNA testing directly to: Dr. van Haeringen Laboratory, PO Box 408, 6700 AK Wageningen, the Netherlands. Make sure you use the special submission forms submission form dog or submission form cat.
Parasitology
The parasitological laboratory is a highly specialised division of the GD laboratory. Here, parasites are detected using direct or indirect methods. The laboratory has extensive experience in the field of effectiveness of antiparasitics and the detection of resistance development. A major part of the tests performed in the parasitology laboratory involves faecal testing for eggs or testing for the presence of other stages of parasite. This can be samples from cattle, sheep, goats, pets, swine, poultry and horses.
Field studies
The parasitological laboratory is very well equipped for studies like prevalence studies, registration studies, or testing anti-parasitic agents in practice. For instance, recently a study has been carried out into a new agent against coccidiosis in swine. GD usually works with recognised, standardised procedures. But if a study requires a new procedure or a new test, developing and applying that is also part of the services package.
Liver fluke forecast
GD has a study group 'liver fluke prognosis'. This study group draws up an expectation of the liver fluke infection pressure on the basis of precipitation data, temperature, snail counts, and lamb liver rejection percentages. Livestock farmers and veterinarians use this prognosis as a basis to draw up their treatment plans.
Testing
Parasites are demonstrated in a direct or an indirect manner. For the direct manner we use the light microscope for identification, for the indirect manner we demonstrate parasite antigen or the antibodies formed against the parasite after an infection.
- Light microscopy
That means identifying the parasite on the basis of its morphology by looking at the specimen under the light microscope. For many parasites we make a distinction between the various development stages of the parasite in question, such as worms, larvae or eggs. - ELISA
In many cases we use ELISAs (Enzyme-linked Immunosorbent Assays) to demonstrate antibodies. ELISAs are based on the principle that the antibodies in question, or parts thereof, attach to a carrier (indirect ELISAs) or compete with a specific labelled antibody (blocking ELISAs). Attached antibodies are then made visible by staining.

Veterinary pathology
In the department of veterinary pathology diagnostic investigations are carried out to determine the cause of illness or death in farm animals, companion animals and horses. In case of farm animals these investigations usually involve post mortem examination, with emphasis on infectious diseases. In companion animals investigations mostly relate to examination of cells and tissues using thin needle aspiration biopsies and surgical biopsies, including tumors and skin biopsies. Pathological examination of farm animals serves animal owners, veterinarians, the food animal sectors and the government. Based on the diagnosis, animal owners and their veterinarians can take targeted therapeutic or preventive measures. The animals sectors and the government obtain information to advance animal disease monitoring and surveillance. Cyto- and histopathology of companion animals and horses is carried out to support clinical follow-up by veterinarians. Results from post mortem examination provide a basis for further evaluation of clinical and therapeutic treatment.
Examinations are carried out by our registered veterinary pathologists, supported by a team of laboratory technicians, necropsy and administrative staff. The facilities include a well-equipped necropsy room for mammalian species and poultry, a histological laboratory and a microscopy room. Additional laboratory testing is carried out in GD's bacteriological, virological, parasitological, molecular-biological and chemical-toxicological laboratory.
In the histological laboratory tissue sections are trimmed and stained for histological examination. In addition to Haemaluin-Eosine routine staining, which turns the cell nuclei blue and the cytoplasm red, there are many other special staining techniques to diagnose certain cell and tissue properties. We also use immunohistochemical techniques on cell and tissue sections to detect tumour markers or microbial organisms.
Pathology: cytology/histology
Thanks to modern high-quality veterinary care, pets are becoming steadily older and the relative prevalence of cancer is increasing. Pets are part of the family and consequently owners expect the same level of medical care for their animal as for themselves and their children.
Treatment plans based on pathological examination
GD offers a high quality and rapid service in the area of tumour pathology. A team of eight pathologists is available, three of whom are specialised in microscopic tumours diagnostics. The entire pathological, histological and cytological examination is carried out at our own facilities. The departments of pathology and histology use diagnostic antibody prevalence to identify non-differentiated tumours. Read more about cytological and histopathological diagnostics
PARR: a PCR for the unravelling of canine lymphoproliferative disorders
Lymphoproliferative disorders represent a significant clinical problem in dogs. It is crucial to differentiate neoplastic lymphoid disease – i.e. lymphomas and leukaemias – from reactive, hyperplastic lymphoid conditions. Nevertheless, the unravelling of nodal or extranodal lymphoproliferative conditions frequently represents a diagnostic challenge for veterinary pathologists. GD’s Animal Health PARR test will supply additional information about the clonal, i.e. neoplastic nature of lymphoid cells, or the polyclonal, i.e. reactive nature of lesional lymphoid cells. While the combination of histopathology and immunohistochemistry is a powerful tool to accurately assess the neoplastic or reactive nature of a lymphoproliferative condition in significant percentage of such cases, the essence of lymphoid neoplasia – i.e. the clonal expansion of neoplastic lymphoid cells – cannot be proved by this microscopic approach. GD’s PARR test will supply additional information in these cases.
Basics of PARR
The canine PARR test is based on the sequences of all loci involved in canine lymphocyte antigen receptor rearrangements. The PARR has been validated in a very large range of canine lymphoproliferative lesions, including all subtypes of canine lymphomas, according to the current WHO classification. So the test has been validated in the various types of large cell lymphomas, small cell lymphomas and indolent lymphomas. Also rare subtypes like angiocentric lymphomas were included in the test panel. Furthermore, the various intestinal and cutaneous lymphomas were included, as well as the recently characterised hepatosplenic canine lymphoma. As a read-out, GD Animal Health decided to use capillary electrophoresis, which is superior to the classical agarose gel electrophoresis.
Additional information
Both paraffin-embedded, formalin-fixed tissue and smears are suited for analysis by PARR. In the case of smears as DNA source for the PARR, we prefer stained smears, as a visual inspection of the smear is necessary to make an assessment of the amount of DNA that can be isolated from the smears. Preferably submit several stained smears. The staining procedures used in cytology do not interfere in a negative way. For formalin-fixed tissues, please submit the wax block, which will be returned once the results of the PARR test have become available. If it is not possible to submit the wax block, please submit three 10µm paraffin sections in an Eppendorf tube and a 4µm HE-stained mounted section of the wax block for a microscopic inspection of the tissue. We report on PARR results in both the T-cell and B-cell populations. The results are reported in 5 to 10 working days (depending on the day of arrival of the tissue). Read more about PARR
Virology
We can apply conventional culturing techniques, develop and use ultramodern techniques and innovations for virological testing. That enables us to offer a wide variety of tests and studies for cultivating, isolating and identifying viruses, and for demonstrating virus antibodies (VNT). For these services, GD uses several techniques, including PCR, virus isolation, virus neutralisation tests, ELISA (both antigen and antibody ELISA), IPMA and agglutination techniques.
We are continuously searching for techniques that make virus testing quicker, cheaper and more efficient. We do this by ‘pooling’ blood samples, for example. Testing is based on a (large) number of blood samples while the price and reliability of the results are the same as that of testing one blood sample. When a signal is detected in a pooled sample, all samples from the pool are tested individually. This is particularly cost-efficient for large batches and for when the percentage of positive samples is low. For free-certification of livestock farms, for instance, but also for comprehensive studies or farm-screening projects. The PCRs for BVD virus in cattle and PRRS virus in swine are tests for which GD Animal Health uses pooling as standard.
Virus isolation and the GD virus bank
Virus isolation is an effective and specific method for the detection of viruses in many samples. For routine testing, virus isolation is used less frequently now because this method is rather expensive, and other excellent alternatives are available. Nowadays, ELISA and PCR are the commonly used techniques to demonstrate virus infections. A rather new service in the GD package is to identify or to type microorganism variants through sequencing techniques and other fingerprinting techniques. We use the virus isolation method, e.g. for vaccine efficacy studies and for collecting field strains for our virus bank. Field strains are stored carefully for use in new studies. The conventional culturing of viruses is also very useful for the detection of new viruses or new virus types.

Water testing
Good drinking water is very important to keep animals healthy. But what is good drinking water? We test various aspects of water, such as the microbial count (colony forming units), content levels of various minerals and Chemical Oxygen Demand (COD). But the main test carried out by GD is the one for suitability as livestock drinking water. Our water testing is based upon on three pillars:
- water must be available at the location where the animals drink: the pipes cannot be clogged up, the flow of the water from the nipple must be good if the animal wants to drink;
- water must not be harmful – this speaks for itself, as the production, growth and health of the animal must not endangered;
- water must be tasty, i.e. the animals are willing to drink the water.
Nowadays the quality of products meant for human consumption (meat, eggs, milk) is being increasingly monitored. These products must be of a high and unsuspicious quality. The water the animals drink must not threaten the quality of the meat. GD Animal Health analyses water designated for livestock drinking water. The results show to what extent the above mentioned criteria are met. Three important reasons why water is submitted for laboratory analysis are:
- Quality control of an existing well
- Quality control of a new well
- Symptoms
Drinking water tests
The main thing a livestock farmer wants to know about the water at his farm, is its suitability as livestock drinking water. If the water is not suitable, GD Animal Health gives advice on options for improving the quality. For water testing, we have developed drinking water packages. A water sample is subjected to many tests: e.g. chemical, bacteriological and organoleptical tests. Individual tests for water samples are possible as well, and individual packages can be created too. Water testing is a fine example of the versatility of GD. The results of various laboratory departments that test the water are combined. That gives a complete picture of the suitability as drinking water. The advice that is linked to the results is specific for every submitted sample.
Testing
Techniques used for water testing include the following;
- Ion chromatography: a chemical compound is used to separate ions such as nitrate, chlorine, and sulphate, and then they are measured using UV detection.
- ICP: for metals and minerals (induced coupled plasma: the sample is dissolved in an acid environment and this acid is atomised in argon plasma of 10,000 °C; then metals and minerals emit specific light that is detected by a chip).
- Automated colorimetric methods: some tests are carried out using a colorimetric method (ammonium, nitrite) in accordance with the Standardised NEN methods prescribed in the Netherlands.
- Bacteriological testing